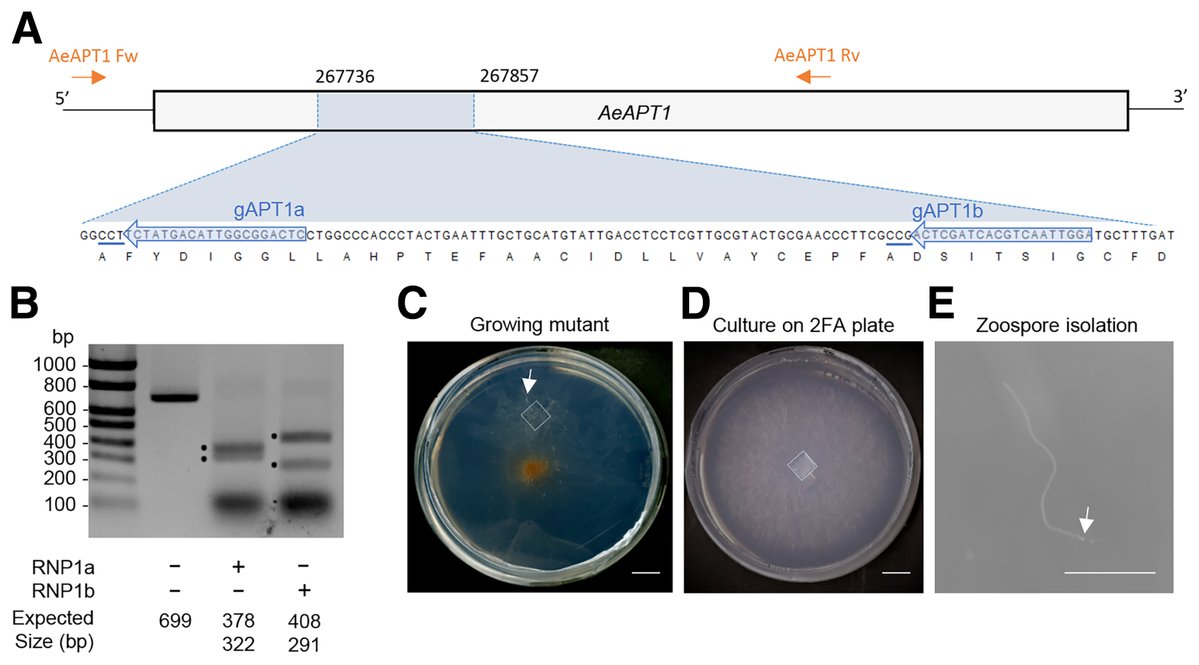
MPMI Journal tweet media

Sabitlenmiş Tweet

International Guided Tour 2026 ✨
June 10-12 📅
Rio Morimoto, 10 June - 2pm
Nathalie Verbruggen, 10 June - 3pm
Panagiotis Moschou, 12 June - 2pm
📍LGDP, UPVD & Zoom 💻
labex-tulip.fr/eng/news/guide…

English
TULIP
1.2K posts

@TULIP_GS_LabEx
International Graduate School & Laboratory of Excellence 🌷 Cutting edge research and education at the interface between ecology, evolution & functional biology

📣 VACANCY: Postdoc/Research Assistant in the Kamoun group @kamounlab Join the team to work on the biology and applications of plant immune receptors 🌱 Apply online by 16 March 2026 tsl.ac.uk/working-at-tsl… #PlantSciJobs #PlantScience #STEMJobs


🆕📰‼️ #PaperCBGP 🌱 Green Revolution crops boosted yields but increased dependence on N-fertilizers 🧬 A new study in @ThePlantCell by the CBGP reveals a molecular mechanism that could help reduce fertilizer use and improve crop stress tolerance 📎 shorturl.at/T4WNM







